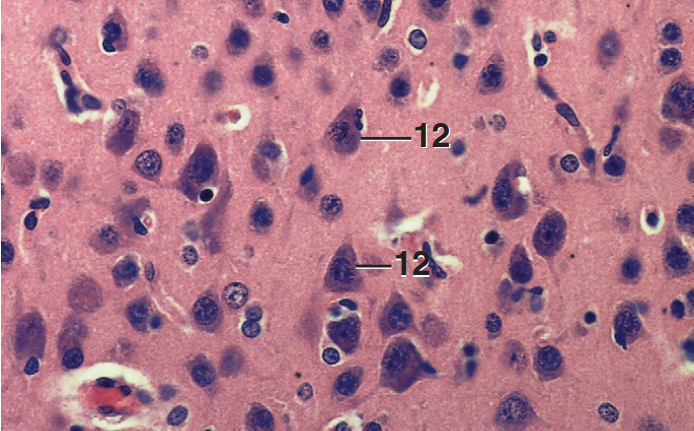
<p></p>

Nervous and Cardiovascular (LAB)
1/78
There's no tags or description
Looks like no tags are added yet.
Name | Mastery | Learn | Test | Matching | Spaced | Call with Kai |
|---|
No analytics yet
Send a link to your students to track their progress
79 Terms

Cerebellum


Cerebellum


Cerebral cortex

Cerebral cortex


Dura mater


What part? Stain?
Meninges, Cerebellum
Mallory’s


Cerebellum


Part and Stain?
Choroid plexus
Cresyl violet


Choroid plexus


Hypothalamus, brain sand


Part and stain?
Medulla, fibrous astrocytes
Golgi stain


Part and Stain?
Spinal cord, cervical
Masson’s


Spinal cord, central canal


Spinal cord, multipolar neurons


Spinal cord, multipolar neurons


Part and stain?
Dorsal root ganglion
Luxol fast blue / Cresylecht violet


Part and stain?
Dorsal root ganglion
Luxol fast blue / cresylecht violet


Pulmonary artery, parasympathetic ganglion


Esophagus, meissner’s plexus x.s


Jejunum, auerbach’s plexus, l.s


Part and Stain?
Nerve, myelinated
Masson’s


Part and Stain?
Nerve fascicle, myelinated
Masson’s

Thoracic wall, nerve myelinated


Part and Stain?
Medulla, axons, myelinated
Hagguist stain


Ureter, nerve fascicle unmyelinated


Schwann cell with unmyelinated axons


Left ventricle, nerve fascicle, unmyelinated


Part and Stain?
Mesentery, pacinian corpuscle, wholemount
Carmine


Pancreas, pacinian corpuscle


Planum, dermis, Small encapsulated nerve endings


Thoracic muscle, neuromuscular spindle


Spinal cord, Glycogen body, lumbosacral enlargement


Glycogen Body, Lumbosacral Enlargement, Spinal Cord xs


Dorsal Root Ganglion, Lumbosacral Enlargement, Spinal Cord, x.s.


Dorsal Root Ganglion, Lumbosacral Enlargement, Spinal Cord, x.s


Herbst Corpuscle, Upper Beak, x.s.,


Herbst Corpuscle, Skin, Neck


Capillaries, x.s. and l.s., Diaphragm,


Capillary, l.s., Lamina Propria, Duodenum


Arterioles and Venules, Eyelid,


Arterioles, x.s., Endometrium, Uterus


Venule, l.s., Connective Tissue, Epiglottis


Arterioles and Venule, l.s., Submucosa, Esophagus,


Small Artery and Vein, x.s., Eyelid,


Small Artery and Vein, x.s., Eyelid,


Small Vein with Valve, l.s., Nose


Small Artery, x.s., with Branch, Subcutis


Small Artery, Vein, and Nerve, x.s., Pancreas


Artery and Vein, x.s., Wattle


Medium Artery, x.s., Lymph Node


Part and Stain?
Medium Artery, x.s., Lymph Node
Orcein


Medium Vein, l.s., Lymph Node


Part and stain?
Medium Vein, l.s., Lymph Node
Orcein


Medium Artery, x.s., Lymph Node


Renal Artery, Near Aorta, x.s.


Portal Vein, x.s.,


Vein with Valves, x.s., Lip


Part and stain?
Umbilical Artery (Right) and Vein (Left), x.s.,
(Masson’s)


Part and stain?
Umbilical Artery, x.s
Masson’s


Glomus, Nose,


Arteriovenous Anastomosis, x.s., Lip,


Part and stain?
Aorta (Left) and Pulmonary Artery (Right), x.s
Orcein


Part and stain?
Aorta, x.s
Orcein


Pulmonary Artery, x.s


Vena Cava, x.s


part and stain?
Right Auricle
Orcein


Part and stain?
Right Auricle
Mallory’s


Pulmonic (Semilunar) Valve, x.s


Part and stain?
Pulmonic (Semilunar) Valve, x.s
Masson’s


Pulmonic (Semilunar) Valve, x.s


Pulmonic (Semilunar) Valve, x.s


Cardiac Skeleton


Purkinje Cells, x.s. and l.s., Left Ventricle


Visceral and Parietal Pericardium


Aortic Body


Aortic Body


Lymphatic Vessel with Valve, Artery, and Vein, Cecal Tonsil


Lymphatic Vessel with Valve, Lymph Node


Large Lymphatic Vessel, Submucosa, Cecum
